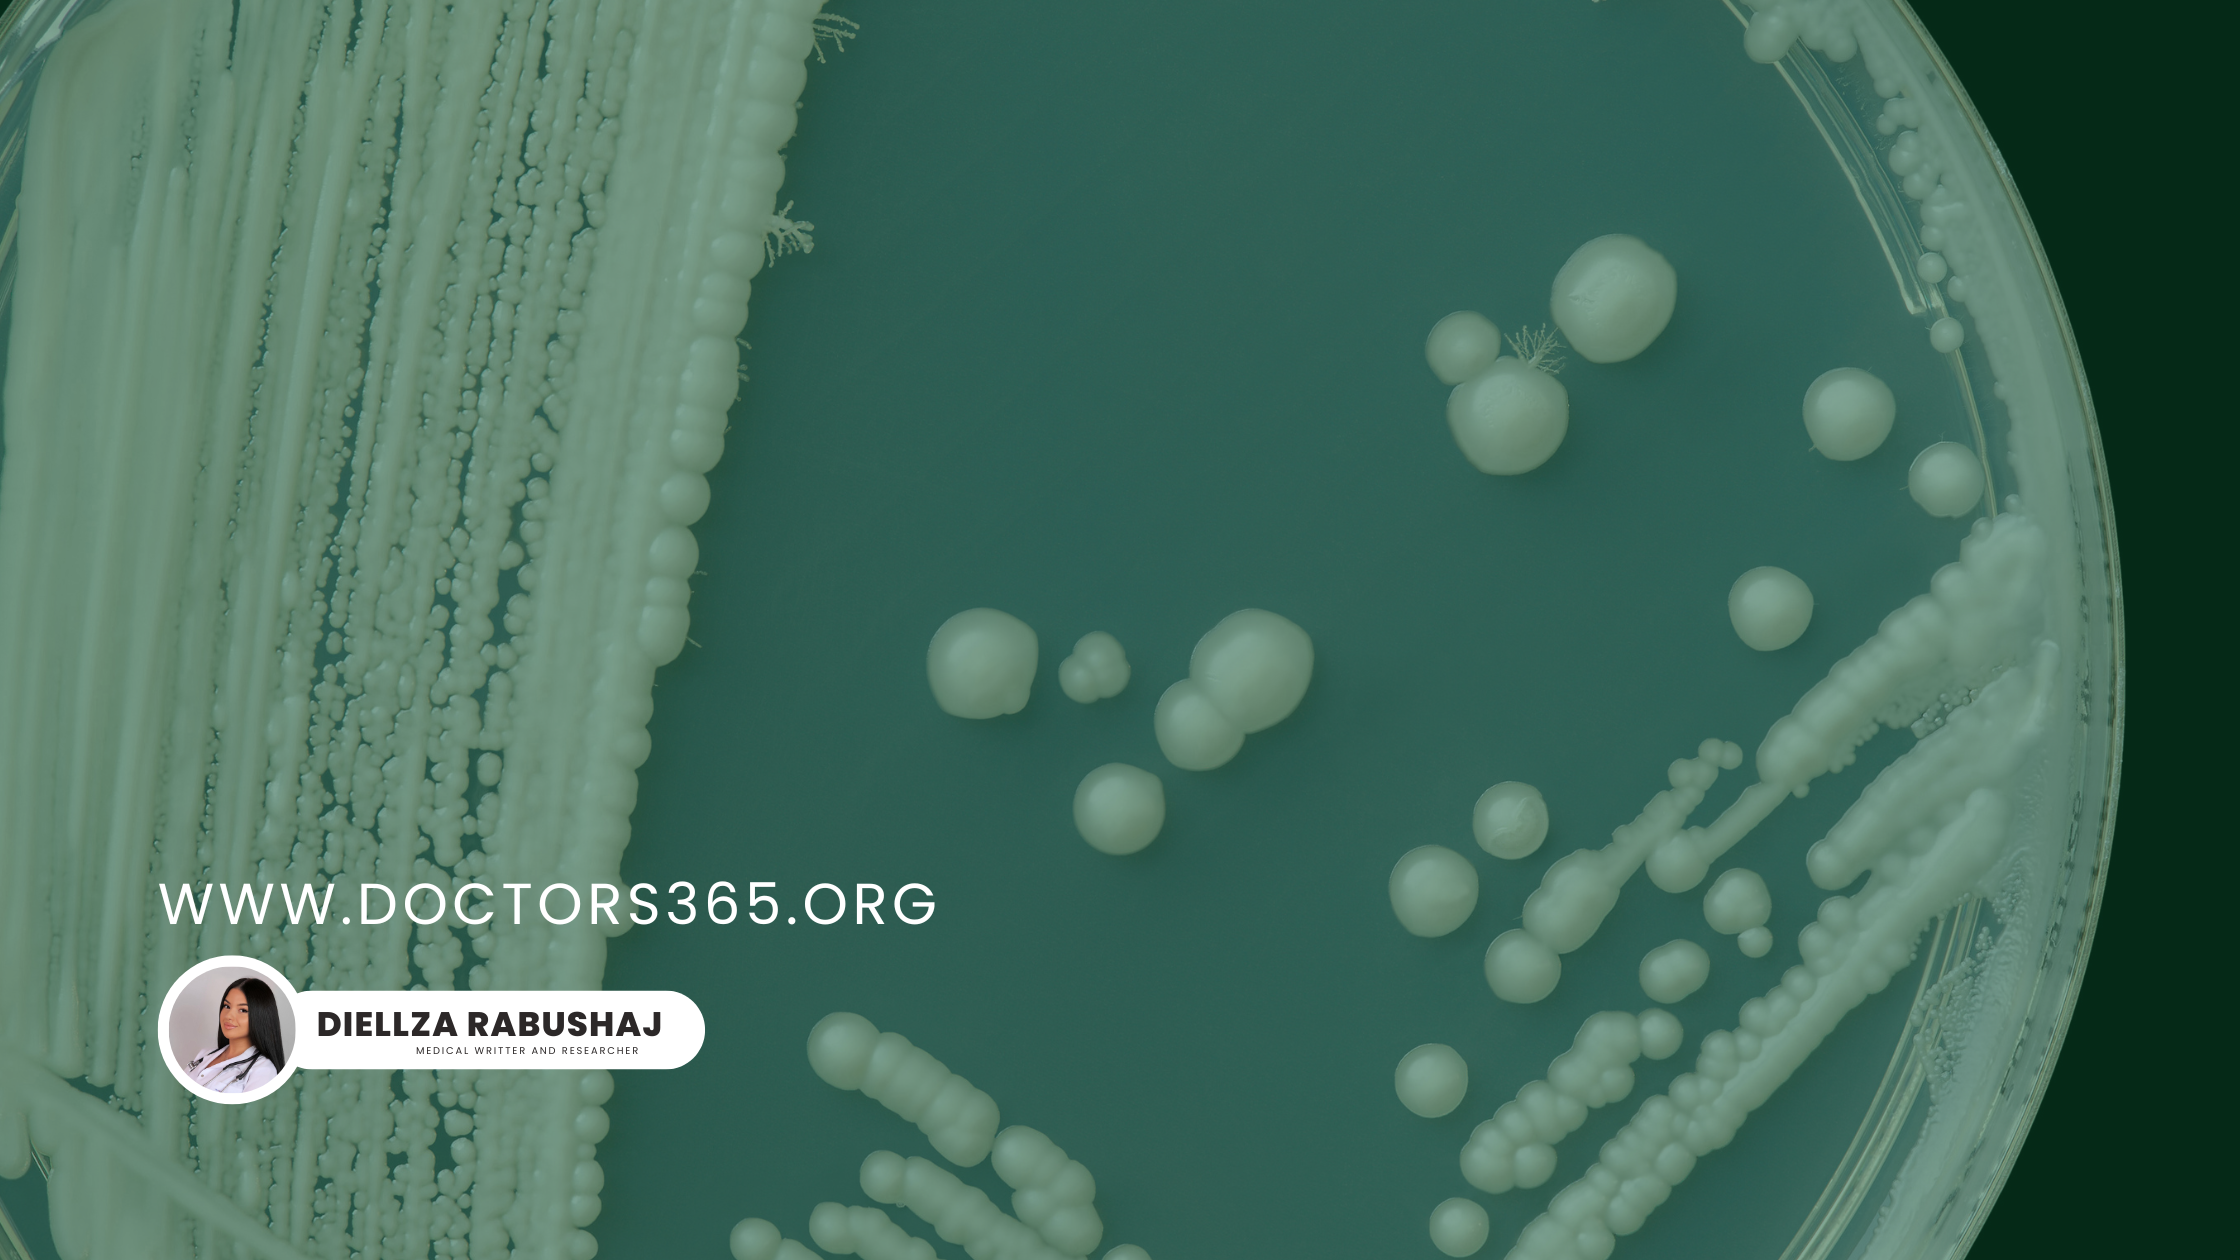

Ophthalmology
Online Ophthalmologist
Fast, Private Virtual Eye Care
Discover convenient, expert eye care from home with online ophthalmologists at Doctors365. Quickly solve vision problems, renew prescriptions, and access virtual consultations without the wait.
Vision Problems Solved Without the Wait—Online Ophthalmologists Are Here to Help
Vision Problems Solved Without the Wait—Online Ophthalmologists Are Here to Help
In today’s fast-paced world, accessibility and convenience are paramount. Vision problems can occur at any time, but finding time to see an ophthalmologist isn’t always easy. Meet an online ophthalmologist for prescriptions, test reviews & eye‑health advice—secure care from home in minutes.Fortunately, online ophthalmologists provide a seamless solution to managing common vision issues and maintaining eye health without leaving the comfort of your home. From prescription renewals to follow-up consultations, virtual eye care is revolutionizing how we approach eye health. At Doctors365, we are committed to providing you with accessible, high-quality ophthalmology services through our telemedicine platform.
What Are Online Ophthalmologists?
Online ophthalmologists are licensed medical doctors (MDs or DOs) specializing in eye and vision care. Unlike optometrists, ophthalmologists can diagnose and treat a wide range of eye conditions, prescribe medications, and even perform surgery—though surgeries require in-person visits. Through telemedicine, they offer services via video calls, digital imaging reviews, and AI-assisted diagnostics, making healthcare more accessible than ever before.
Services Provided by Online Ophthalmologists
- Prescription Renewals: Glasses and contact lens prescriptions can be renewed through virtual consultations, making it convenient for patients to maintain their vision correction needs.
- Non-Emergency Assessments: Conditions like dry eyes, eye allergies, and minor infections can be effectively managed online.
- Diagnostic Test Reviews: Online ophthalmologists can interpret visual field results, optical coherence tomography (OCT) scans, and other diagnostic tests.
- Second Opinions: Virtual platforms provide an excellent resource for obtaining additional medical insights, particularly for complex cases【1】.
The Benefits of Virtual Eye Care
Telemedicine has introduced a range of benefits that make online eye care a preferred choice for many patients.
1. Convenience for Routine Needs
From the comfort of your home, you can schedule consultations and receive diagnoses and prescriptions without the need to travel. This is particularly useful for individuals with mobility challenges or those living in rural areas with limited access to eye care specialists【2】.
2. Cost-Effective Follow-Ups
For stable eye conditions such as glaucoma or dry eyes, follow-up visits can be conducted remotely, reducing costs by up to 30% as reported by recent studies【3】.
3. Faster Prescription Updates
Lost or expired prescriptions? Online services can provide same-day prescription renewals after a quick visual acuity test, saving both time and resources【3】.
4. Improved Accessibility
Telemedicine eliminates barriers for patients who may find it difficult to travel to a physical clinic. During the COVID-19 pandemic, virtual consultations reduced wait times by as much as 68% for non-urgent cases【2】.
When to Use Online Ophthalmology Services
While online eye care is convenient and effective, it is essential to know when to use it and when a physical examination is necessary.
Suitable for Online Consultations:
- Prescription renewals for glasses or contact lenses.
- Managing dry eyes, allergies, or mild infections.
- Reviewing diagnostic tests (e.g., visual field tests, OCT scans).
- Post-surgery check-ins if approved by your surgeon【4】.
When to Visit a Clinic In-Person:
- Sudden vision loss.
- Eye trauma such as chemical burns or injuries.
- Presence of flashes or floaters, which could indicate retinal detachment.
- Severe pain or light sensitivity【4】.
How Virtual Eye Care Works
Navigating online eye care services is straightforward. Here’s how you can make the most of your virtual ophthalmology consultation:
Step 1: Choose a reputable platform linked to certified online ophthalmologists
Ensure the platform is affiliated with credible medical institutions or reputable ophthalmologists. Services associated with academic centers or certified ophthalmologists provide the most reliable care【5】.
Step 2: Prepare Your Technology
- Smartphone or computer with a camera.
- Stable internet connection.
- A well-lit room for visual assessments【5】.
Step 3: During the Consultation
- Utilize a Snellen chart for visual acuity tests.
- Share clear photos of eye symptoms (e.g., redness, swelling) through secure platforms.
- Discuss symptoms using the OPQRST framework (Onset, Provocation, Quality, Radiation, Severity, Time)【5】.
Step 4: Post-Visit Follow-Up
- Receive e-prescriptions directly to your pharmacy.
- Schedule an in-person visit if necessary【5】.
Limitations of Online Eye Care
While tele-ophthalmology offers numerous benefits, there are some limitations to be aware of:
- Inability to Perform Certain Tests: Comprehensive exams such as dilated retinal exams or detecting severe conditions like cataracts or macular degeneration are not possible online【6】.
- High Prescriptions: Virtual consultations may not accurately assess patients with prescriptions higher than -6.00 diopters【6】.
- Pediatric Assessments: Children under the age of 12 should be seen in person for proper diagnosis and care【6】.
Tips for Maintaining Eye Health Between Visits
Maintaining eye health requires a proactive approach. Here are some simple preventative measures you can take:
- Eat a Balanced Diet: Incorporate leafy greens like spinach and kale for better macular health.
- Follow the 20-20-20 Rule: Every 20 minutes, look at something 20 feet away for 20 seconds.
- Use Blue Light Filters: Especially important if you spend long hours in front of screens.
- Manage Chronic Conditions: Diabetics should maintain proper blood sugar levels to prevent retinopathy【7】.
The Future of Tele-Ophthalmology
Emerging technologies are constantly improving the efficacy and accessibility of online eye care. Innovations such as:
- AI Diabetic Retinopathy Screeners: Algorithms analyzing retinal images are showing high accuracy in early trials【8】.
- Home Tonometers: Soon-to-be FDA-approved devices allowing patients to self-test eye pressure【8】.
- VR Visual Field Tests: Applications designed to replicate in-clinic assessments from home【8】.
Conclusion
Tele-ophthalmology offers a convenient, affordable, and effective solution for managing many common eye conditions. While it cannot replace all aspects of traditional eye care, it certainly provides a valuable alternative for routine care and follow-ups. By combining online consultations with regular in-person visits, patients can achieve comprehensive eye health management. Visit Doctors365 to experience the best in virtual eye care today!
References
- WebMD. Online Vision Tests Review. Available at: https://www.webmd.com/eye-health/online-vision-tests
- PMC. Virtual Ophthalmic Services. Available at: https://pmc.ncbi.nlm.nih.gov/articles/PMC7561601/
- PubMed. Telemedicine in Optometry/Ophthalmology. Available at: https://pubmed.ncbi.nlm.nih.gov/10747536/
- MedlinePlus. Eye Care Guidelines. Available at: https://medlineplus.gov/eyecare.html
- WebMD. Ophthalmologist vs. Optometrist. Available at: https://www.webmd.com/a-to-z-guides/what-is-ophthalmologist
Written by Diellza Rabushaj, Medical Writer & Researcher.
Recommended articles for You

Safe, private medication abortion at home—guided by licensed doctors via secure video consults. WHO-endorsed care, 95–98% effective.
Learn about candida vaginosis and how online doctors can help.

Stop leaks from home—get expert continence care on Doctors365.